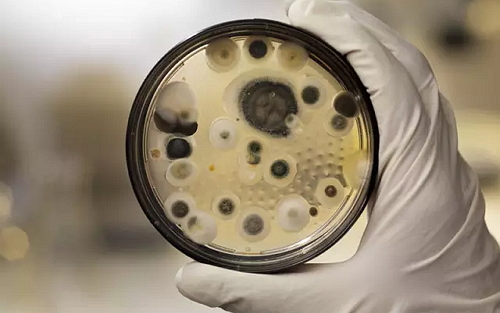

1、把握疾病谱变化的大方向是医药投资的根本 对于研究工作,最重要的是把握住行业大趋势或者说行业大方向,这是我这几年行业研究工作下来最大的体会。用公司领导的话来说,刻画出时代背景,是研究的首要工作。对于医药行业来说,也不例外。 决定医药产业长期发展的因素很多,如需求、政策、资本、创新等等,而其中又以需求最为根本。医药产业之所以能够长青,根本原因在于,随着社会的发展、财富的增加,活得更健康,成为人类日益突出的需求,从而对战胜病痛、延长寿命的投入也越来越大。简而言之,持续旺盛的需求是支撑医药行业长期走牛的最大逻辑。 而与旺盛的医药需求对应的,是人类的疾病谱及其变化。疾病谱,是指疾病在不同人群、不同时期的发病率与死亡率。疾病谱并非一成不变,而是随着人口结构、生活方式、生存环境及医疗技术的变化而不断变化。 疾病谱引导着医药的研发投入方向,同时也给医药投资提供了明确的线索。沿着疾病谱的变化趋势,提前布局,才有望抓住医药行业的大势。 2、美国、日本、中国疾病谱的变化 在人类早期,抗生素未被发明以前,传染性疾病是导至人类死亡的主要疾病,历史上的几次黑死病的爆发甚至改变了人类文明的进程。即使在20世纪50年代,急性传染病仍高居死因的第二位,白喉、结核病、脑炎、肺炎等传染性及感染性疾病,仍是早亡的主要原因。 但近年,威胁人们生命的却是心脑血管疾病、肿瘤、糖尿病、退行性疾病等慢性疾病,慢病导至的死亡人数占到总死亡人数八成。 2014年,美国前十死亡原因包括心脏病、恶性肿瘤、慢性下呼吸道疾病(慢性阻塞性肺病等)、脑血管疾病、阿尔茨海默病、糖尿病、肾病等慢性疾病,而且因恶性肿瘤、慢性阻塞性肺病、糖尿病、肾病等死亡的人数随着时间推移明显增加。 从日本的数据看,过去20年,结核、病毒性肝炎等传染性疾病大幅下降,恶性肿瘤、糖尿病、脂蛋白代谢紊乱、痴呆、情感障碍、阿尔茨海默病、慢性肾功能衰竭等慢性疾病的发病率稳步增加。 表1:美国居民前十大死亡原因:心脏、肿瘤、呼吸道超过意外伤害排前三  资料来源:美国CDC 表2:日本接受治疗的病人按病种分(千人):慢性病持续增加  资料来源:日本厚生劳动省 从我国居民的两周患病率看,这一趋势也非常明显。传染病、寄生虫病、呼吸系统疾病、急性胃炎等感染性疾病患病率大幅下降,而恶性肿瘤、糖尿病、精神病、心脏病、高血压、脑血管疾病等疾病的患病率急速增加。 表3:我国居民的两周患病率(‰):感染性疾病下降,而慢性病上升  资料来源:国家卫计委 3、疾病谱变迁的原因 疾病谱的变迁,与医疗技术进步、人口年龄结构变化、生活习惯等密切相关。首先,随着社会的发展及医疗技术的进步,多数感染类疾病已被人类控制,曾经全球肆虐的天花病毒已经在全球范围内被消灭,丙肝病毒有望随着直接抗病毒药物的广泛应用而被征服,心脑血管疾病的危害在成熟国家也初步被遏制。 其次,不同疾病在不同年龄段的人群的发病率有显著的差异。年龄越大,糖尿病、高血压、肿瘤、慢性肾病等慢性疾病的发病率越高。2003-2013年,我国居民不同年龄段的慢性病患病率相对稳定,但由于人口的老龄化,总人群的慢病患病率增加了1倍。再次,不健康的生活习惯也会对疾病谱有显著的影响。 比如,现代人糖分和热量摄入过多而运动不足导至肥胖,进而对血压、血脂、胰岛素抵抗等产生负面影响,冠状动脉性心脏病、缺血性中风、2型糖尿病甚至恶性肿瘤的风险都会随着体重指数(BMI)增加而稳步加大。 表4:我国居民不同年龄组的慢性病患病率(‰):慢病率随年龄快速增加  资料来源:国家卫计委 表5:我国居民的慢性疾病患病率(‰):过去10年快速上升  资料来源:国家卫计委  图1:肥胖已经成为全球问题 资料来源:WHO 4、全球医药巨头的形成及其资本市场表现 疾病谱深刻影响着医药工业的发展轨迹。20世纪40-70年代,威胁人类健康的主要疾病为细菌感染性疾病,那个时代最火的产品为抗生素类产品。 70-80年代,以高血压为代表的心血管疾病发病率上升,选择性β-受体阻断剂、钙通道拮抗剂、血管紧张素转化酶抑制剂等高血压药物不断涌现,取代抗生素成为畅销药物榜单的常客,1990年全球最畅销20药品中,高血压类药物达到6个。 进入到90年代以后,由于世界各国工业化进程的加快和国民生活水平的普遍提高,高血脂及抑郁症等精神疾病逐渐成为主要疾病,降血脂及抗抑郁药物开始爆发,成为畅销药的生力军。 而现在,随着人口的进一步老龄化,恶性肿瘤、糖尿病、类风湿关节炎等慢性疾病的发病率持续上升,这些领域成为重磅炸弹的主要来源,2015年全球前10大药品中,自身免疫疾病药物和肿瘤用药分别占有4席,甘精胰岛素作为糖尿病用药代表位列第5。 表6:不同时期的全球最畅销的20大药品:时代特征浓缩在药品清单里  资料来源:互联网搜索、各大药企年报等 顺应疾病谱演变、迎合新的临床需求的药企,能够不断发展壮大以至成为全球巨头,而那些没能跟随疾病变化及时调整研发策略的公司,在竞争中不断衰败甚至消亡。 辉瑞及诺和诺德,因为顺应了大势而成就了各自的辉煌。上世纪上半叶,细菌感染仍是人类的最大威胁,辉瑞创新性地利用发酵工艺生产青霉素,产量极大且生产成本低,向美国军方提供大量廉价的青霉素,公司利用这一机会飞速扩张;此后,公司又先后推出土霉素、四环素等大品种,一举奠定了辉瑞在全球医药的霸主地位。 进入到80-90年代,辉瑞成功抓住了高血压、抑郁、高血脂药物市场的爆发,先后推出(或收购)硝苯地平、左洛复、络活喜、立普妥等一系列疗效确切、符合时代需求的重磅炸弹,90年代辉瑞股价上涨超过10倍。  图2:辉瑞制药的股价与重要品种:制药龙头的“与时俱进” 资料来源:辉瑞年报、广发证券研究中心 诺和诺德的发展史是一部人类治疗糖尿病的历史,也是糖尿病疾病谱演化的最佳见证。从最早从牛胰腺中提取胰岛素,到合成人胰岛素,到口服降糖药、GLP-1类似物,再到胰岛素类似物、超长效胰岛素,诺和诺德都在引领着行业的发展。诺和诺德之所以能够成为全球前十大的医药公司,在于契合了全球糖尿病大爆发的时代背景。糖尿病患者数量的快速增加,带来对胰岛素等糖尿病药物的巨大需求,推动诺和诺德的业绩持续增长,股价长期走牛。  图3:诺和诺德糖尿病产品线发展史 资料来源:国金证券研究所  图4:诺和诺德股价与糖尿病患病率(以美国为例) 资料来源:美国CDC, wind 5、中国医药产业回顾与前瞻 中国的医药工业发展经历了类似的历程。1958年,共和国医药长子华北制药厂的建成,结束了我国青霉素完全依赖进口的历史,也开启了我国医药工业发展的篇章,抗生素、磺胺、解热药、维生素、抗结核药等是当时主要的明星品种,为防治严重危害人民健康的传染病,做出了重要贡献。 改革开放后,随着经济的发展和社会环境的变化,人们对药品的需求也发生了变化,口服避孕药、心脑血管病用药、抗病毒用药等开始快速增长。而近10多年,人口的老龄化及生活方式的变化导至慢性疾病发病率上升,肿瘤、血脂代谢异常、糖尿病、神经系统、慢性肾病等领域用药成为行业的主要增长点。 行业需求端的变化,深刻影响了身在其中的企业的命运。1995年,抗生素龙头华北制药占了A股医药板块市值的头把交椅;而今天,以肿瘤药为主的恒瑞医药成为无可辩驳的老大。 回到中国医药市场,目前整个行业处于改革调整期,招标降价、医保控费、二次议价、医保支付价、降药占比、临床数据核查、仿制药一致性评价等政策不断,医药现有的格局将会受到巨大的冲击,整个行业面临洗牌。 面对这些,对制药行业的未来不免困惑甚至悲观,但只要目光往远处望,对中国制药行业又将充满信心,因为持续旺盛的需求。未来30年,中国人口步入加速老龄化的阶段。到2050年,中国60岁以上人口数量将超过4亿,占总人口比例近40%。  图5:中国步入人口老龄化加速阶段 资料来源:中国人口老龄化与产业结构调整的统计研究.杨光辉 这个过程中,中国居民的疾病谱的演变路径将非常清晰,感染性疾病、消化系统疾病的发病率有望缓步下降,而恶性肿瘤、糖尿病、慢性肾病、老年神经系统疾病、精神障碍等慢性疾病的患病率将持续爆发,病人基数在一个很长的周期里都将呈现稳步增加的趋势。 中国的用药结构与全球对比,存在显著的差异,比如抗感染药物、消化系统用药及免疫调节剂等占比过高,一方面部分反应了中国当前疾病谱与全球的差异,但也说明了抗生素、质子泵抑制剂及辅助用药在中国存在过度使用的情况。 长期看这类药物的相对比重将持续下降;而跟全球比,糖尿病、类风湿关节炎、疼痛、呼吸系统、精神健康、老年神经退行性疾病等用药领域在中国仍有显著的成长空间,与中国疾病谱及变化趋势相吻合。 表7:中国与全球的用药结构对比:反差里蕴藏变化  资料来源:IMS、Pharma Database 表8:中国疾病谱:中国常见疾病的发病率/患病率及趋势  资料来源:Global Demographics 抓住中国现在与未来疾病谱的大方向,深度前瞻研究各个细分领域与具体企业,是医药投资的关键。过去10年,中国政府对医疗卫生事业的投入持续加大,医保覆盖率从30%不到增加到今天的近100%,旺盛的需求驱动了医药行业整体的高速发展,医药企业享受了十年的甜蜜高速增长。 展望未来,随着经济放缓,医保基金收入增速下滑,而需求端的增长依然较快,控费成为常态,药品行业将长期步入中低速增长期,行业的不合理之处终将得到纠正,药企之间将出现明显的分化,行业集中度有望快速提升。 变革之下,药企的发展模式将从“销售驱动”转向“研发驱动”,能做出真正满足临床需求的药品成为核心竞争力。国内一批药企已经提前布局,在临床需求旺盛的领域上持续多年高投入,已经积累了潜力巨大的在研产品线。 随着药企理念和机制的逐步完善,海外技术骨干陆续回国壮大人才队伍,以及医药风险投资基金的兴起,中国有望在生物靶向药、免疫治疗、基因编辑等前沿领域实现突破。 再加上中国老龄化带来的巨大且持续增长的需求,有理由相信,在肿瘤、糖尿病、呼吸系统、精神健康等大领域,能成长出一批世界级的中国药企。在未来的医药投资时,沿着疾病谱按图索骥,才有望提前发现机会,抓住下一波中国医药创新与国际化的大趋势。 |
 /3
/3 